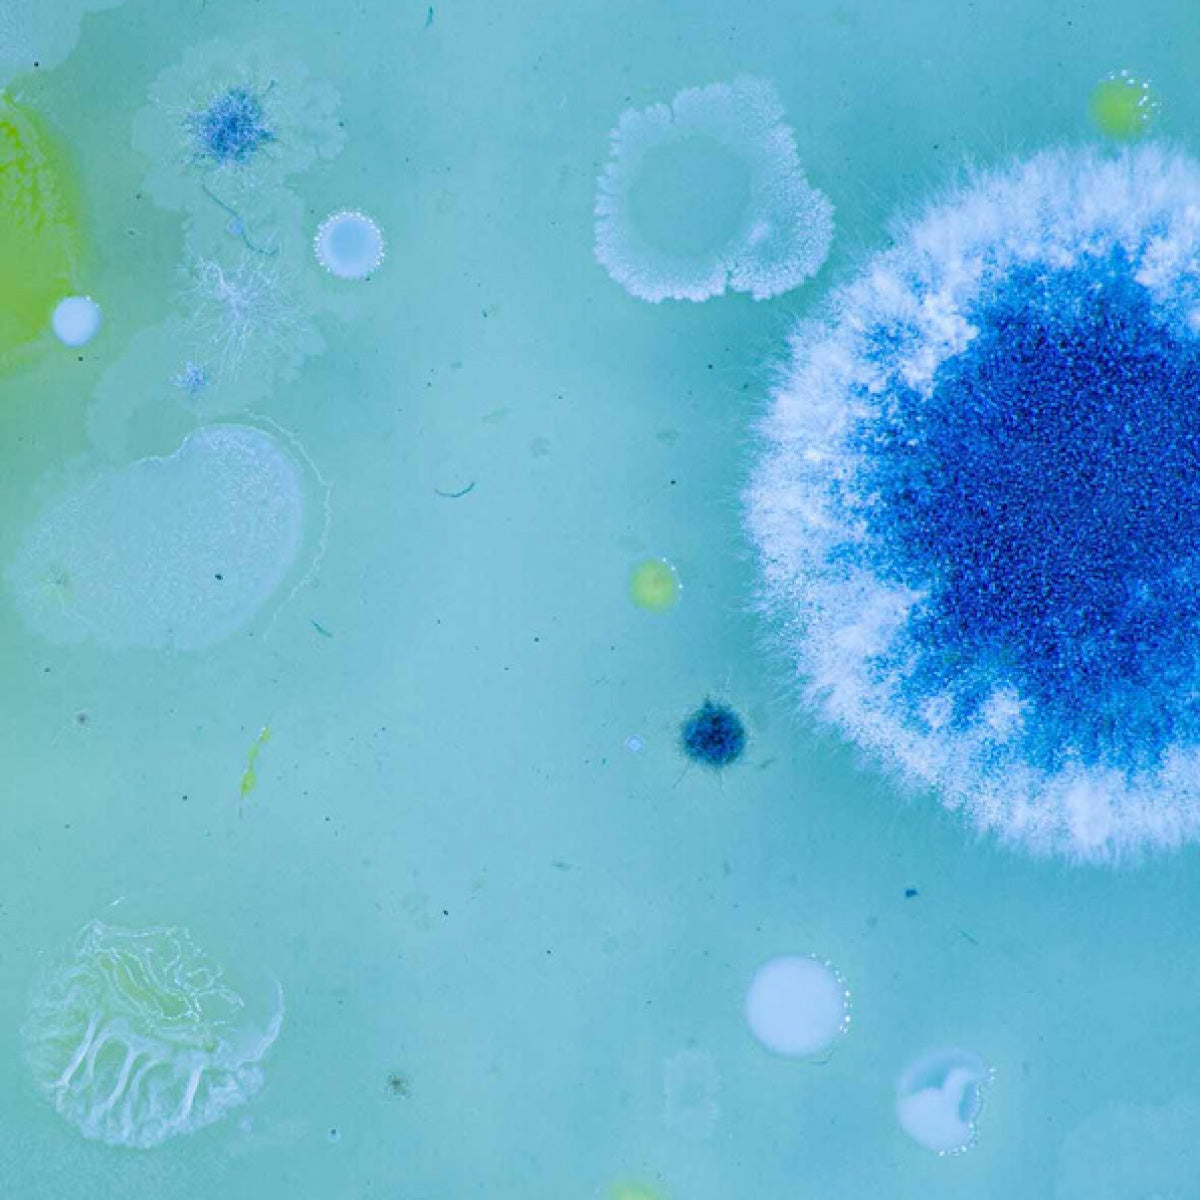

Skaza
Bokashi kliid Biogen 1 kg
Efektiivsete mikroorganismidega looduslik starter biojäätmete fermenteerimiseks ehk kääritamiseks Bokashi kompostris.
Tõhusaks käärimisprotsessiks raputa kliid kompostri põhja, iga lisatud jäätmekihi vahele ning kompostri täitumisel kõige peale. Kliide lisamisega hoiad ära biojäätmete mädanemise ning seetõttu ka ebameeldivad lõhnad ning äädikakärbsed.
Kasutamisalad:
- Bokashi kompostris biojäätmete kääritamiseks
- Komposti kiirendamiseks aiakompostris
- Taimede kasvu soodustamiseks, kui seda kasutatakse vähemalt 14 päeva enne külvamist või istutamist
- Septikute hoolduseks ja kanalisatsioonist halva lõhna eemaldamiseks
Koostisosad: Fermenteeritud nisukliid ja fermenteerivad mikroobid (laktobatsillide ja pärmide segu, mis on CUC-i poolt sertifitseeritud). See on 100% looduslik GMO-vaba toode, mille valmistamisel ei ole kasutatud kemikaale ning mis sobib kasutada mahetootmises.
Säilita originaalpakendis, toatemperatuuril ning tarvita pärast esmast avamist 6 kuu jooksul. Sulge pakend õhukindlalt et vältida kliide kuivamist.
Toodetud Euroopa Liidus, Hollandis.
Biogen Bokashi kliid on kvaliteetne segu nisukliidest ning efektiivsetest mikroorganismidest, mis tagavad eduka käärimisprotsessi Bokashi kompostris ja hoiavad ära biojäätmete mädanenise.
Pärast käärimisprotsessi lõppu säilitavad biojäätmed kõik olulised toitained, mis on vajalikud taimede kasvuks, ent mis tradistioonilise kompostimise teel oleks kadunud. Efektiivsed mikroorganismide toel saab toidujäätmetest probiootiline väetis, täis looduslikke kasulikke mikroobe, aminohappeid, vitamiine ja ensüüme. Mulda lisatuna komposteerub Bokashi kompostris käärinud biomass väga kiiresti ning 2-3 kuuga saad Bokashi meetodil valmistada esmaklassilise komposti ilma energiat, süsinikku ja lämmastikku atmosfääri vabastamata ehk tõenäoliselt kõige keskkonnasõbralikumal moel.
Video
Mis on efektiivsed mikroorganismid?













